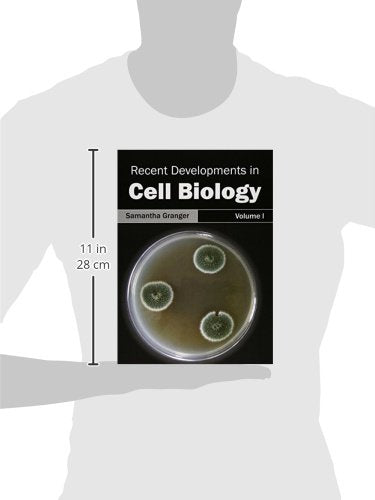
Recent Developments in Cell Biology: Volume I: 1 - Retail Maharaj

কোষ জীববিজ্ঞানের সাম্প্রতিক উন্নয়ন: খণ্ড ১: ১
কোষ জীববিজ্ঞানের সাম্প্রতিক উন্নয়ন: খণ্ড ১: ১ is backordered and will ship as soon as it is back in stock.
Couldn't load pickup availability
Genuine Products Guarantee
Genuine Products Guarantee
We guarantee 100% genuine products, and if proven otherwise, we will compensate you with 10 times the product's cost.
Delivery and Shipping
Delivery and Shipping
Products are generally ready for dispatch within 1 day and typically reach you in 3 to 5 days.
লেখক: গ্রেঞ্জার, সামান্থা
ব্র্যান্ড: ক্যালিস্টো রেফারেন্স
বাঁধাই: হার্ডকভার
ফর্ম্যাট: আমদানি করুন
পৃষ্ঠা সংখ্যা: ২২০
প্রকাশের তারিখ: ১৬-০৩-২০১৫
অংশ সংখ্যা: রঙিন চিত্র
ইএএন: ৯৭৮১৬৩২৩৯৫৩০৬
প্যাকেজের মাত্রা: ১১.৪ x ৮.৯ x ০.৭ ইঞ্চি
ভাষা: ইংরেজি